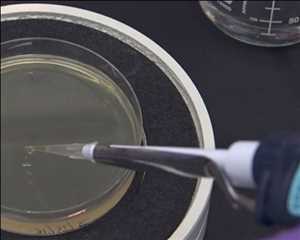
Global-Cloned-Competent-Cells-Market

Global Células competentes clonadas Market 2022 es un recurso sistemático y autorizado que muestra inteligencia de marketing para los nuevos participantes de la industria, así como para las empresas establecidas. El estudio cubre las principales iniciativas de los actores de la industria, como Merck KGaA, Thermo Fisher Scientific, Agilent Technologies, Takara Bio, Promega Corporation, Beijing TransGen Biotech, GeneScript Corporation, Yeastern Biotech, New England Biolabs, QIAGEN N.V., OriGene Technologies, Lucigen, Zymo Research, Bio-Rad Laboratories, Bioline , así como un análisis de su impacto. El estudio también incluye una descripción general corporativa, participación en las ganancias y análisis FODA de los principales actores en la industria Células competentes clonadas . Toda la cadena de valor del mercado también se describe en el informe de investigación de mercado global Células competentes clonadas, junto con el análisis de los componentes ascendentes y descendentes del mercado Células competentes clonadas.
Obtenga un informe de investigación de muestra exclusivo: www.syndicatemarketresearch.com/sample/cloned-competent-cells-market
PRONÓSTICO DE CRECIMIENTO FUTURO:
La investigación comienza con una perspectiva del mercado y luego pasa a las perspectivas de crecimiento del mercado Células competentes clonadas. La investigación pronostica un alto crecimiento futuro del mercado Células competentes clonadas en todas sus categorías geográficas y de productos mediante la combinación de integración de datos y algoritmos inteligentes con descubrimientos apropiados. Además, para generar el estudio se utilizaron varias características importantes que determinarán el sector Células competentes clonadas, así como métodos de regresión para predecir las tendencias de desarrollo del mercado.
La investigación analiza el escenario actual del negocio mundial Células competentes clonadas, así como los principales factores que están afectando el mercado. La investigación también incluye predicciones analíticas para el mercado Células competentes clonadas durante los próximos cinco años. Estas predicciones explican el hecho de cada detalle sobre el mercado Células competentes clonadas e incluyen los aportes necesarios de destacados expertos de la industria.
El mercado global Células competentes clonadas tiene las siguientes partes para mostrar (por tabla de contenido resumida):
Parte 1: definición, especificaciones, clasificación de Células competentes clonadas, segmento de mercado por regiones;
Parte 2: Materiales y proveedores, estructura de costos de fabricación, técnicas de fabricación, marco del ciclo de vida del producto;
Parte 3: Células competentes clonadas Detalles tecnológicos y análisis de plantas de fabricación, volumen y descripción comercial del producto, utilización de instalaciones de fabricación, actividad de I+D y fuente de información, análisis de canales de materias primas;
Parte 4: Perfil de jugadores clave de la industria que incluye descripción general, finanzas, cartera de productos, estrategia comercial, desarrollos recientes;
Parte 5: Análisis de Mercado Regional que incluye América del Norte, Países Bajos, Europa, China, Japón, Sudeste Asiático, India, Estados Unidos y Resto del Mundo;
Parte 6: El análisis de mercados del segmento Células competentes clonadas (por aplicación): Subclonación y clonación de rutina, construcción de bibliotecas de exhibición de fagos, clonación de ADN tóxico/inestable, clonación de alto rendimiento
Parte 7: análisis de tendencias de mercados, tendencias de mercados regionales, tendencias de mercado por tipo de producto: 20*100µl, 50*100µl, 100*100µl, Otro ;
Parte 8: El análisis del consumidor del mercado global Células competentes clonadas;
Parte 9: Células competentes clonadas Hallazgos y conclusiones de la investigación, Apéndice, metodología y fuente de datos;
Parte 10: Células competentes clonadas canal de ventas, distribuidores, comerciantes, comerciantes, resultados de la investigación y conclusión.

Pronósticos estadísticos: en el estudio de investigación, los pronósticos estadísticos están disponibles para el mercado Células competentes clonadas total junto con sus segmentos clave. El documento repasa los segmentos clave, sus perspectivas de crecimiento y las nuevas oportunidades que presentan a los participantes del mercado. La investigación también incluye un análisis del efecto de adquisiciones recientes de transacciones de fusiones y adquisiciones, como empresas conjuntas. El documento también incluye sugerencias útiles para la gestión de nuevos programas que pueden ayudar a las empresas a optimizar las operaciones existentes y la estructura de ingresos.
Panorama competitivo: El panorama competitivo del mercado descrito en el estudio analiza los competidores más importantes del mercado. El estudio de investigación cubre la descripción general del negocio, los desarrollos actuales, las estrategias principales y la participación en los ingresos de los principales actores de la industria en el mercado global Células competentes clonadas. Además, los últimos eventos y su impacto en la industria global Células competentes clonadas se han presentado en el informe. Además, el documento incluye consejos estratégicos que ayudarán a los recién llegados y a las empresas existentes a maximizar su retorno de la inversión. El informe de mercado Células competentes clonadas brinda una imagen completa de la industria a través de la investigación, la síntesis y el resumen de datos de varias fuentes. Los especialistas se han ofrecido a los distintos sectores con el objetivo específico de identificar a los manipuladores significativos del sector. El informe de mercado Células competentes clonadas incluye un panorama completo del mercado y de los proveedores, así como un análisis FODA de los principales competidores. Como resultado, la información ofrecida es completa, confiable y el resultado de una extensa investigación.
El informe de mercado Células competentes clonadas proporciona un análisis detallado de los factores específicos que están cambiando y lo coloca por delante de la competencia. El estudio también está organizado con una estimación de CAGR (tasa de crecimiento anual compuesta) para el mercado Células competentes clonadas en porcentaje durante el período de tiempo especificado.
Esta es una plataforma importante que se esfuerza por cubrir una amplia gama de temas, que incluyen atención médica, tecnología, productos químicos y transporte. Nos aseguramos de que nuestros clientes reciban informes de información bien investigados, confiables y firmes centrándonos en el desarrollo y la innovación. Esto les ayuda a tomar mejores decisiones.
Sobre nosotros
Establecer un pie fuerte en la industria con todos los enfoques planificados y tácticos seguramente no es pan comido. Necesita mucha investigación, análisis, tener en cuenta varios factores y, sobre todo, dedicar su valioso tiempo a todo el proceso. Aquí es donde Syndicate Market Research entra en acción como un sistema de apoyo para nuestros clientes. A veces, conocer solo los fundamentos de un mercado no es suficiente y nada puede ser más útil que un informe comercial inteligente que proporcione todos los aspectos de ese mercado o industria en particular. Y prometemos ayudar a nuestros clientes a caminar por el pasillo hacia el éxito ofreciéndoles todas las tendencias y diversas oportunidades que se pueden aprovechar además de las restricciones que pueden obstaculizar el crecimiento del mercado.